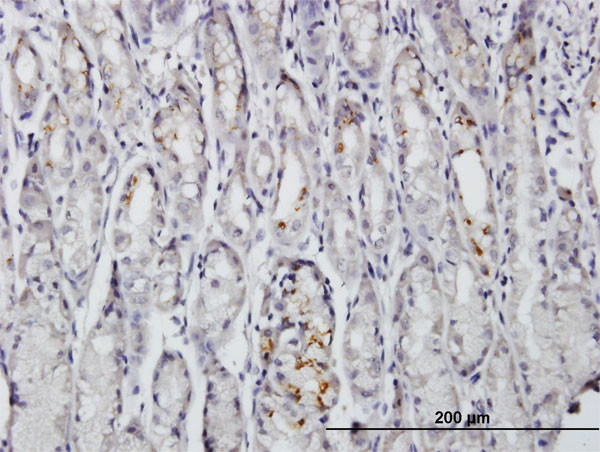
BAG4 Antibody in Immunohistochemistry (Paraffin) (IHC (P))

Search
Abnova
BAG4 Polyclonal Antibody, MaxPab™
{{$productOrderCtrl.translations['antibody.pdp.commerceCard.promotion.promotions']}}
{{$productOrderCtrl.translations['antibody.pdp.commerceCard.promotion.viewpromo']}}
{{$productOrderCtrl.translations['antibody.pdp.commerceCard.promotion.promocode']}}: {{promo.promoCode}} {{promo.promoTitle}} {{promo.promoDescription}}. {{$productOrderCtrl.translations['antibody.pdp.commerceCard.promotion.learnmore']}}
产品信息
H00009530-B01P
种属反应
宿主/亚型
分类
类型
抗原
偶联物
形式
浓度
规格
纯化类型
保存液
内含物
保存条件
运输条件
产品详细信息
Sequence of this protein is as follows: MSALRRSGYG PSDGPSYGRY YGPGGGDVPV HPPPPLYPLR PEPPQPPISW RVRGGGPAET TWLGEGGGGD GYYPSGGAWP EPGRAGGSHQ EQPPYPSYNS NYWNSTARSR APYPSTYPVR PELQGQSLNS YTNGAYGPTY PPGPGANTAS YSGAYYAPGY TQTSYSTEVP STYRSSGNSP TPVSRWIYPQ QDCQTEAPPL RGQVPGYPPS QNPGMTLPHY PYGDGNRSVP QSGPTVRPQE DAWASPGAYG MGGRYPWPSS APSAPPGNLY MTESTSPWPS SGSPQSPPSP PVQQPKDSSY PYSQSDQSMN RHNFPCSVHQ YESSGTVNND DSDLLDSQVQ YSAEPQLYGN ATSDHPNNQD QSSSLPEECV PSDESTPPSI KKIIHVLEKV QYLEQEVEEF VGKKTDKAYW LLEEMLTKEL LELDSVETGG QDSVRQARKE AVCKIQAILE KLEKKGL
靶标信息
The protein encoded by this gene is a member of the BAG1-related protein family. BAG1 is an anti-apoptotic protein that functions through interactions with a variety of cell apoptosis and growth related proteins including BCL-2, Raf-protein kinase, steroid hormone receptors, growth factor receptors and members of the heat shock protein 70 kDa family. This protein contains a BAG domain near the C-terminus, which could bind and inhibit the chaperone activity of Hsc70/Hsp70. This protein was found to be associated with the death domain of tumor necrosis factor receptor type 1 (TNF-R1) and death receptor-3 (DR3), and thereby negatively regulates downstream cell death signaling. The regulatory role of this protein in cell death was demonstrated in epithelial cells which undergo apoptosis while integrin mediated matrix contacts are lost.
仅用于科研。不用于诊断过程。未经明确授权不得转售。
篇参考文献 (0)
生物信息学
蛋白别名: BAG family molecular chaperone regulator 4; BAG-4; Bcl-2-associated athanogene 4; BCL2 associated athanogene 4; Silencer of death domains; unnamed protein product
基因别名: BAG-4; BAG4; SODD
UniProt ID: (Human) O95429
Entrez Gene ID: (Human) 9530